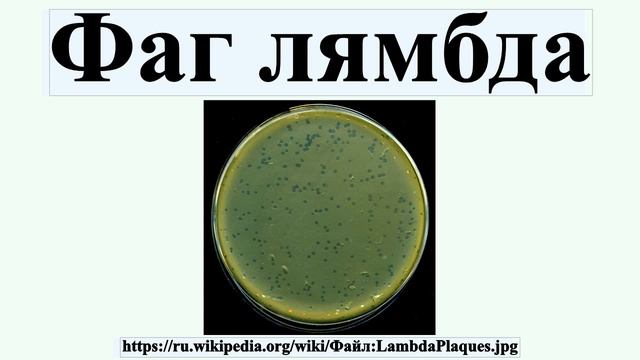
Фаг лямбда смотреть онлайн

Автор / Канал: Ремонтные Революции Страница 7

finish powder coating

фактура фрески выветренная скала

Простое приспособление к пылесосу для чистки компьютера и труднодоступных мест.Просто и дешево !

? Фантастические твари и где обитает Обскур. Психологический обзор фильма. Обскуры

КИТАЙСКАЯ ТУРИСТИЧЕСКАЯ РАСКЛАДУШКА, УКРЕПЛЕНИЕ, РЕМОНТ, ОБЗОР, СТОИТ ЛИ ПОКУПАТЬ?

Видео работы установки автоматической передвижной кареточного типа для опрыскивания хлеба водой (1)

Малина Завалит Вас Урожаем! Важная Подкормка Малины в Июне Во Время Цветения

Машина для прошивки базальтового полотна

Грибы вешанка собранные с дерева грецкого ореха

Миллион на свиньях.Отлучка поросят от свиноматки.Обзор супоросной свиноматки породы пьетрен.

Отопление гаража Самый дешевый способ! #Shorts

Креативный подход - 100 идей для ДАЧи которые захочется повторить

Ответы на вопросы. Почему зеленеет вода в пруду? Помогут ли толстолобик и амур в очистке пруда и др

алюминиевые весла для лодки с уключинами Янтарь-2, @Lodka44video

Микрозелень. Выращивание дома. Горчица.

Зона открытой окраски - 15 000 часов в работе - сделано у нас для ЧМЗ

Форма дла силиконовых приманок из жидкого гвоздя. Эксперимент провалился. Рыбалка с Денчиком

ЗАЧЕМ ДИЕТЫ ЕСЛИ ЕСТЬ ДАЧНЫЙ ФИТНЕС

ПОЛЕЗНЫЕ ПОКУПКИ?IKEA I LEROY MERLIN?потратили 500€ в Leroy Merlin и вышли с пустыми руками
Фаг лямбда

Юмилия/эдит

Биогумус - вермикомпост - свойства, как сделать, применение - на даче и дома

How to cancel a print job in Windows 11 | HP Printers | HP Support

собачья будка своими руками!!
За каждым успешным каналом стоит личность, идея и сотни часов кропотливого труда. Если вы здесь, значит, автор «Ремонтные Революции» уже сумел зацепить ваше внимание своим уникальным стилем или подачей. А мы на RUVIDEO позаботились о том, чтобы вы могли изучить весь архив его работ в максимально комфортных условиях — без лишней суеты и преград.
Почему за работами канала «Ремонтные Революции» так интересно наблюдать? Всё просто: это честный контент, который находит отклик в сердцах зрителей. На нашем ресурсе вы можете смотреть онлайн все видео любимого автора бесплатно и в хорошем качестве. Нам важно, чтобы вы видели каждую деталь и слышали каждый нюанс, поэтому мы используем только стабильные плееры из открытых источников Rutube.
Следите за новинками канала, пересматривайте старые шедевры и открывайте для себя новые грани творчества «Ремонтные Революции». Мы постоянно обновляем ленту, чтобы у вас под рукой всегда были самые свежие выпуски. Никаких сложных регистраций — только вы и творчество, которое вдохновляет. Приятного вам путешествия по миру авторского контента на RUVIDEO!
Видео взято из открытых источников Rutube. Если вы правообладатель, обратитесь к первоисточнику.